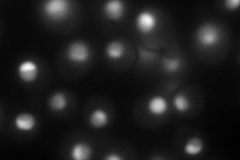

View description
Essential nucleolar protein of unknown function; contains WD repeats, interacts with Mpp10p and Bfr2p, and has homology to Spb1p
Localization:
Intensity:
Fold change:
Significance:
-
C’ GFP library in SD

below threshold16.1 -
N' NOP1pr-GFP in SD
nucleolus153.812 -
N' TEF2pr-mCherry in SD

nucleus,nucleolus133.361 -
N' NATIVEpr-GFP in SD

nucleolus83.6688 -
N' TEF2pr-VC and Cyto-VN in SD

nucleus,nucleolus37.5082 -
C’ GFP library in SD+DTT

cytosol17.741.1No -
C’ GFP library in SD+H2O2

cytosol21.241.31No -
C’ GFP library in Starvation Media

cytosol16.931.05No -
C’ GFP library on the background of Pup2-DaMP

below threshold -
C’ GFP library on the background of CCT mutant

below threshold17.37911.0791No
